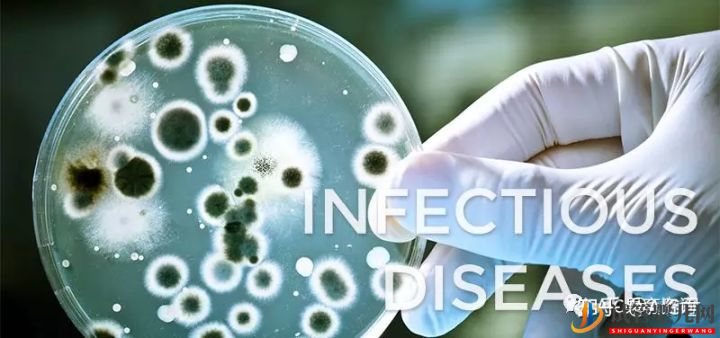
美國試管嬰兒FDA規定要做的那些檢查(圖6)

?
国产免费成人在线视频|
精品国产凹凸成av人网站|
非洲一级黄色片|
久久wwww|
91精品国产91久久久久久久久|
污视频网站免费观看|
激情久久久久久久久久久久久久久久|
成人短视频在线观看免费|
国产高清自拍视频在线观看|
欧美男女性生活在线直播观看|
天天看片中文字幕|
成人精品亚洲|
成人18视频|
av网站一区|
精品福利在线视频|
成年人网站在线观看视频|
亚洲黄页网站|
亚洲综合中文字幕68页|
18成人免费观看视频漫画|
一区二区三区不卡视频|
人妻大战黑人白浆狂泄|
久草精品视频|
成人情趣片在线观看免费|
蜜桃视频涩涩|
亚洲尤物视频在线|
成人激情五月天|
日韩美女毛片|
95av在线视频|
丁香资源影视免费观看|
色哟哟一区二区在线观看|
国产十六处破外女视频|
婷婷综合伊人|
日韩欧美在线电影|
东凛在线观看|
日韩av在线看|
亚洲第一色视频|
国产成人一级电影|
亚洲午夜精品一区|
国产精品一区免费在线|
国产精品av在线播放|
黑人巨大40cm重口|
午夜精品久久久久久久久久久|
任你操精品视频|
91国语精品自产拍|
亚洲精品欧美精品|
日本在线免费播放|
国产性猛交xxxx免费看久久|
天天操天天干天天爽|
91亚洲男人天堂|
亚洲av无码成人精品区|
成人涩涩网站|
91久久国产综合久久蜜月精品|
国产女主播在线|
欧美日韩高清一区二区三区|
亚洲毛片一区二区三区|
免费观看在线色综合|
aaa毛片在线观看|
成人精品高清在线视频|
国产91色在线免费|
成人黄18免费网站|
欧美精品精品一区|
91福利在线观看视频|
国产乱一区二区|
在线免费黄色小视频|
y111111国产精品久久久|
国产日韩中文字幕在线|
曰韩少妇与小伙激情|
欧美tickling网站挠脚心|
a级片免费观看|
91香蕉视频污|
少妇精品一区二区三区|
99精品小视频|
经典三级在线视频|
亚洲一二三四|
热草久综合在线|
国产h色视频在线观看|
911精品国产一区二区在线|
亚洲一级av毛片|
成人一级黄色片|
a级片在线观看视频|
欧美日韩伦理|
综合久久国产|
中文字幕人成乱码在线观看|
情事1991在线|
91破解版在线看|
亚洲成人黄色在线观看|
亚洲电影先锋|
亚洲美女在线国产|
日产精品久久久久|
紧缚捆绑精品一区二区|
亚洲美女高潮久久久|
精品国产一区二区三区久久久樱花|
日本在线成人一区二区|
欧美aaaaaaa|
日韩美女激情视频|
传媒在线观看|
亚洲欧美日韩在线高清直播|
免费精品国产自产拍在|
欧美性69xxxx肥|
亚洲天堂网在线视频|
youjizz久久|
五月激情四射婷婷|
亚洲永久字幕|
欧美激情第3页|
国产乱码精品一区二区亚洲|
精品一区二区成人免费视频|
四虎4545www国产精品|
亚洲最大福利网站|
香蕉视频在线播放|
午夜精品久久久久久久99热
|
亚洲激情六月丁香|
日韩在线视频免费播放|
国产传媒一区在线|
免费网站在线高清观看|
久久精品日产第一区二区|
国产成人美女视频|
久久国产成人午夜av影院宅|
91亚洲精品国产|
成年永久一区二区三区免费视频
|
欧洲av在线播放|
亚洲激情图片小说视频|
乱子伦一区二区三区|
91在线播放网址|
1024手机在线视频|
国产乱理伦片在线观看夜一区|
日韩网站在线播放|
国产精品久久久久久久免费软件|
在线黄色免费看|
青青草成人影院|
116极品美女午夜一级|
日本精品影院|
欧美 亚洲 视频|
中文字幕一区二区三区中文字幕|
色一情一乱一伦一区二区三欧美
|
国产情侣一区|
99久久综合网|
国语对白精品一区二区|
欧美成人乱码一二三四区免费|
久久伦理在线|
白嫩少妇丰满一区二区|
国产探花在线精品一区二区|
亚洲精品久久久久久久蜜桃臀|
www国产精品|
超碰97在线看|
av日韩在线播放|
懂色av粉嫩av蜜臀av|
精品国产三级|
青少年xxxxx性开放hg|
久久影院一区二区三区|
宅男一区二区三区|
日韩影片在线观看|
特级西西444|
日韩精选在线|
欧洲黄色一级视频|
日韩在线高清|
不卡的在线视频|
黄色在线一区|
黄色性视频网站|
美女久久一区|
手机看片福利视频|
国产精品资源网站|
手机在线免费看毛片|
成人av电影免费观看|
国产大片中文字幕在线观看|
91视频在线看|
一级成人黄色片|
日韩美女视频19|
国产女人18毛片水真多|
天天综合天天综合色|
五月天婷婷在线播放|
欧美日韩久久久一区|
国产乱在线观看完整版视频|
亚洲成人激情图|
麻豆资源在线|
久久综合久久美利坚合众国|
日本天堂在线|
国产精品美乳在线观看|
zzzwww在线看片免费|
久久久综合亚洲91久久98|
国产va免费精品观看精品|
8x8x华人在线|
欧美激情在线精品一区二区三区|
国产成人精品无码播放|
欧美日韩1区|
给我免费观看片在线电影的|
久久精品国产一区二区|
男人操女人的视频网站|
久久久精品免费免费|
国产又大又黑又粗|
色婷婷亚洲综合|
国产男女av|
亚洲网在线观看|
日本私人影院在线观看|
国产97在线亚洲|
九色porny丨国产首页在线|
欧美一区二区三区在线播放|
97品白浆高清久久久久久|
鲁一鲁一鲁一鲁一澡|
欧美日韩一区自拍|
特级西西人体4444xxxx|
国产美女av一区二区三区|
日韩av免费网址|
亚洲综合激情另类小说区|
亚洲色欧美另类|
欧美变态口味重另类|
成人午夜影院|
日韩av电影院|
天堂8中文在线最新版在线|
亚洲精品一区二区三|
欧美精美视频|
先锋资源在线视频|
国产乱码精品一区二区三区av|
久久国产视频精品|
欧美性生交大片免网|
国产精品18久久久久久久久久|
在线播放亚洲激情|
成人免费高清在线播放|
国产视频一区二区不卡|
都市激情亚洲欧美|
亚洲va在线va天堂va偷拍|
欧美aaa在线|
日本黄色片视频|
午夜欧美一区二区三区在线播放|
国产又猛又黄又爽|
色婷婷av一区二区三区在线观看|
国产福利免费在线观看|
国产亚洲欧美一区二区三区|
国产成人高清精品免费5388|
伊人成人222|
国产美女一区二区|
亚洲综合视频在线播放|
欧美日韩精品三区|
18av.com视频|
国产精品久久久久av免费|
欧美日韩尤物久久|
精品99在线视频|
三级一区在线视频先锋|
国产a∨精品一区二区三区仙踪林|
精品日韩中文字幕|
岛国在线免费|
欧美怡红院视频一区二区三区|
免费看av不卡|
日本www在线播放|
日韩电影一区二区三区四区|
六月丁香在线视频|
欧美伊人精品成人久久综合97|
天天操夜夜操免费视频|
国产精品福利在线观看|
日韩三级成人|
91高清国产视频|
国产成人午夜视频|
国产精品免费无遮挡|
精品久久一二三区|
九色视频在线播放|
日本午夜精品一区二区三区|
97久久夜色精品国产|
久久精品日韩无码|
亚洲午夜电影在线观看|
免费网站看黄yyy222|
91av福利视频|
日本成人一区二区|
伊人五月天婷婷|
99久久国产综合精品色伊
|
欧美大码xxxx|
欧美aa一级|
男人揉女人奶房视频60分|
美女一区二区久久|
国产又黄又大又爽|
亚洲激情国产精品|
激情成人四房播|
91精品一区二区三区四区|
欧美一级网站|
波多野结衣高清在线|
日韩精品在线一区二区|
久久精品蜜桃|
亚洲一区三区视频在线观看|
精品成人免费|
国产黄色免费观看|
欧美一区二区久久久|
免费在线超碰|
亚洲精品一区二区三区樱花|
精品999日本|
久久国产视频一区|
日韩欧美精品三级|
成av人电影在线观看|
在线免费一区|
日韩国产欧美在线观看|
国产免费叼嘿网站免费|
亚洲欧洲国产一区|
国产盗摄一区二区|
女人另类性混交zo|
99精品一区二区|
欧美午夜性春猛xxxx|
久久久久久成人|
国产精品亚洲综合在线观看|
白嫩情侣偷拍呻吟刺激|
自拍偷拍亚洲综合|
草草浮力影院|
99视频在线免费观看|
99九九热只有国产精品|
日本一级淫片色费放|
日韩欧美国产三级|
caoporn免费在线|
日韩精品一区二区三区久久|
成人性生交大片免费看中文|
在线视频在线视频7m国产|
7777精品久久久久久|
永久免费精品视频|
日本一卡二卡在线播放|
色综合久久久网|
能在线看的av|
国内少妇毛片视频|
国产.欧美.日韩|
日韩在线第二页|
国产成人av网|
欧美激情在线免费|
日韩成人一区二区三区|
精品裸体舞一区二区三区|
av在线免费观看网址|
九色在线视频观看|
久久亚洲精品国产精品紫薇|
一个人看的www在线免费视频|
91精品久久久久|
欧美韩国日本在线观看|
中文字字幕在线中文|
亚洲精品视频二区|
日韩影片中文字幕|
色婷婷精品久久二区二区密|
亚洲18色成人|
欧美91精品久久久久国产性生爱|
欧美日韩中文字幕在线播放|
国产99久久久国产精品免费看|
久久综合精品视频|
成人做爰www免费看视频网站|
在线中文字幕第一区|
中文字幕久久熟女蜜桃|
日韩综合视频在线观看|
精品91福利视频|
日韩一卡二卡在线观看|
日韩一区二区视频在线观看|
欧美野外wwwxxx|
国产不卡的av|
亚洲第一福利视频在线|
色资源在线观看|
18禁免费无码无遮挡不卡网站|
久久久国产午夜精品|
成人免费黄色网址|
奇米视频888战线精品播放|
免费精品视频最新在线|
亚洲第一欧美|
亚洲在线观看视频网站|
亚洲国产高清一区|
免费成人在线看|
国产精品白嫩初高中害羞小美女|
欧美韩日一区|
国产视频在线一区|
5252色成人免费视频|
日本高清免费电影一区|
中文字幕日韩三级|
欧美大奶子在线|
久久99国内|
中文字幕一区二区三区四区欧美|
久久精品成人一区二区三区|
97久久亚洲|
精品国产乱码一区二区|
日韩一区在线视频|
高清精品视频|
亚洲天堂一区在线|
久热在线中文字幕色999舞|
看全色黄大色大片免费久久久|
国产无码精品视频|
影音先锋日韩有码|
日韩成人精品|
国产精品不卡av|
中文字幕日韩电影|
开心激情综合|
97人妻精品视频一区|
欧美国产乱视频|
日韩国产专区|
av中文字幕观看|
国产免费一区视频观看免费
|
久久精品久久久久久久|
欧美另类xxx|
郴州新闻综合频道在线直播|
国产男女裸体做爰爽爽|
国产mv免费观看入口亚洲|
欧美日韩一卡|
最近更新在线中文字幕一页|
99re在线视频观看|
老司机精品视频一区二区三区|
l8videosex性欧美69|
奇米精品在线|
91免费看片在线观看|
亚洲精品少妇久久久久久|
国产精品丝袜久久久久久消防器材|
亚洲色图制服丝袜|
黄色片在线播放|
成人在线短视频|
337p亚洲精品色噜噜狠狠|
亚洲伦理影院|